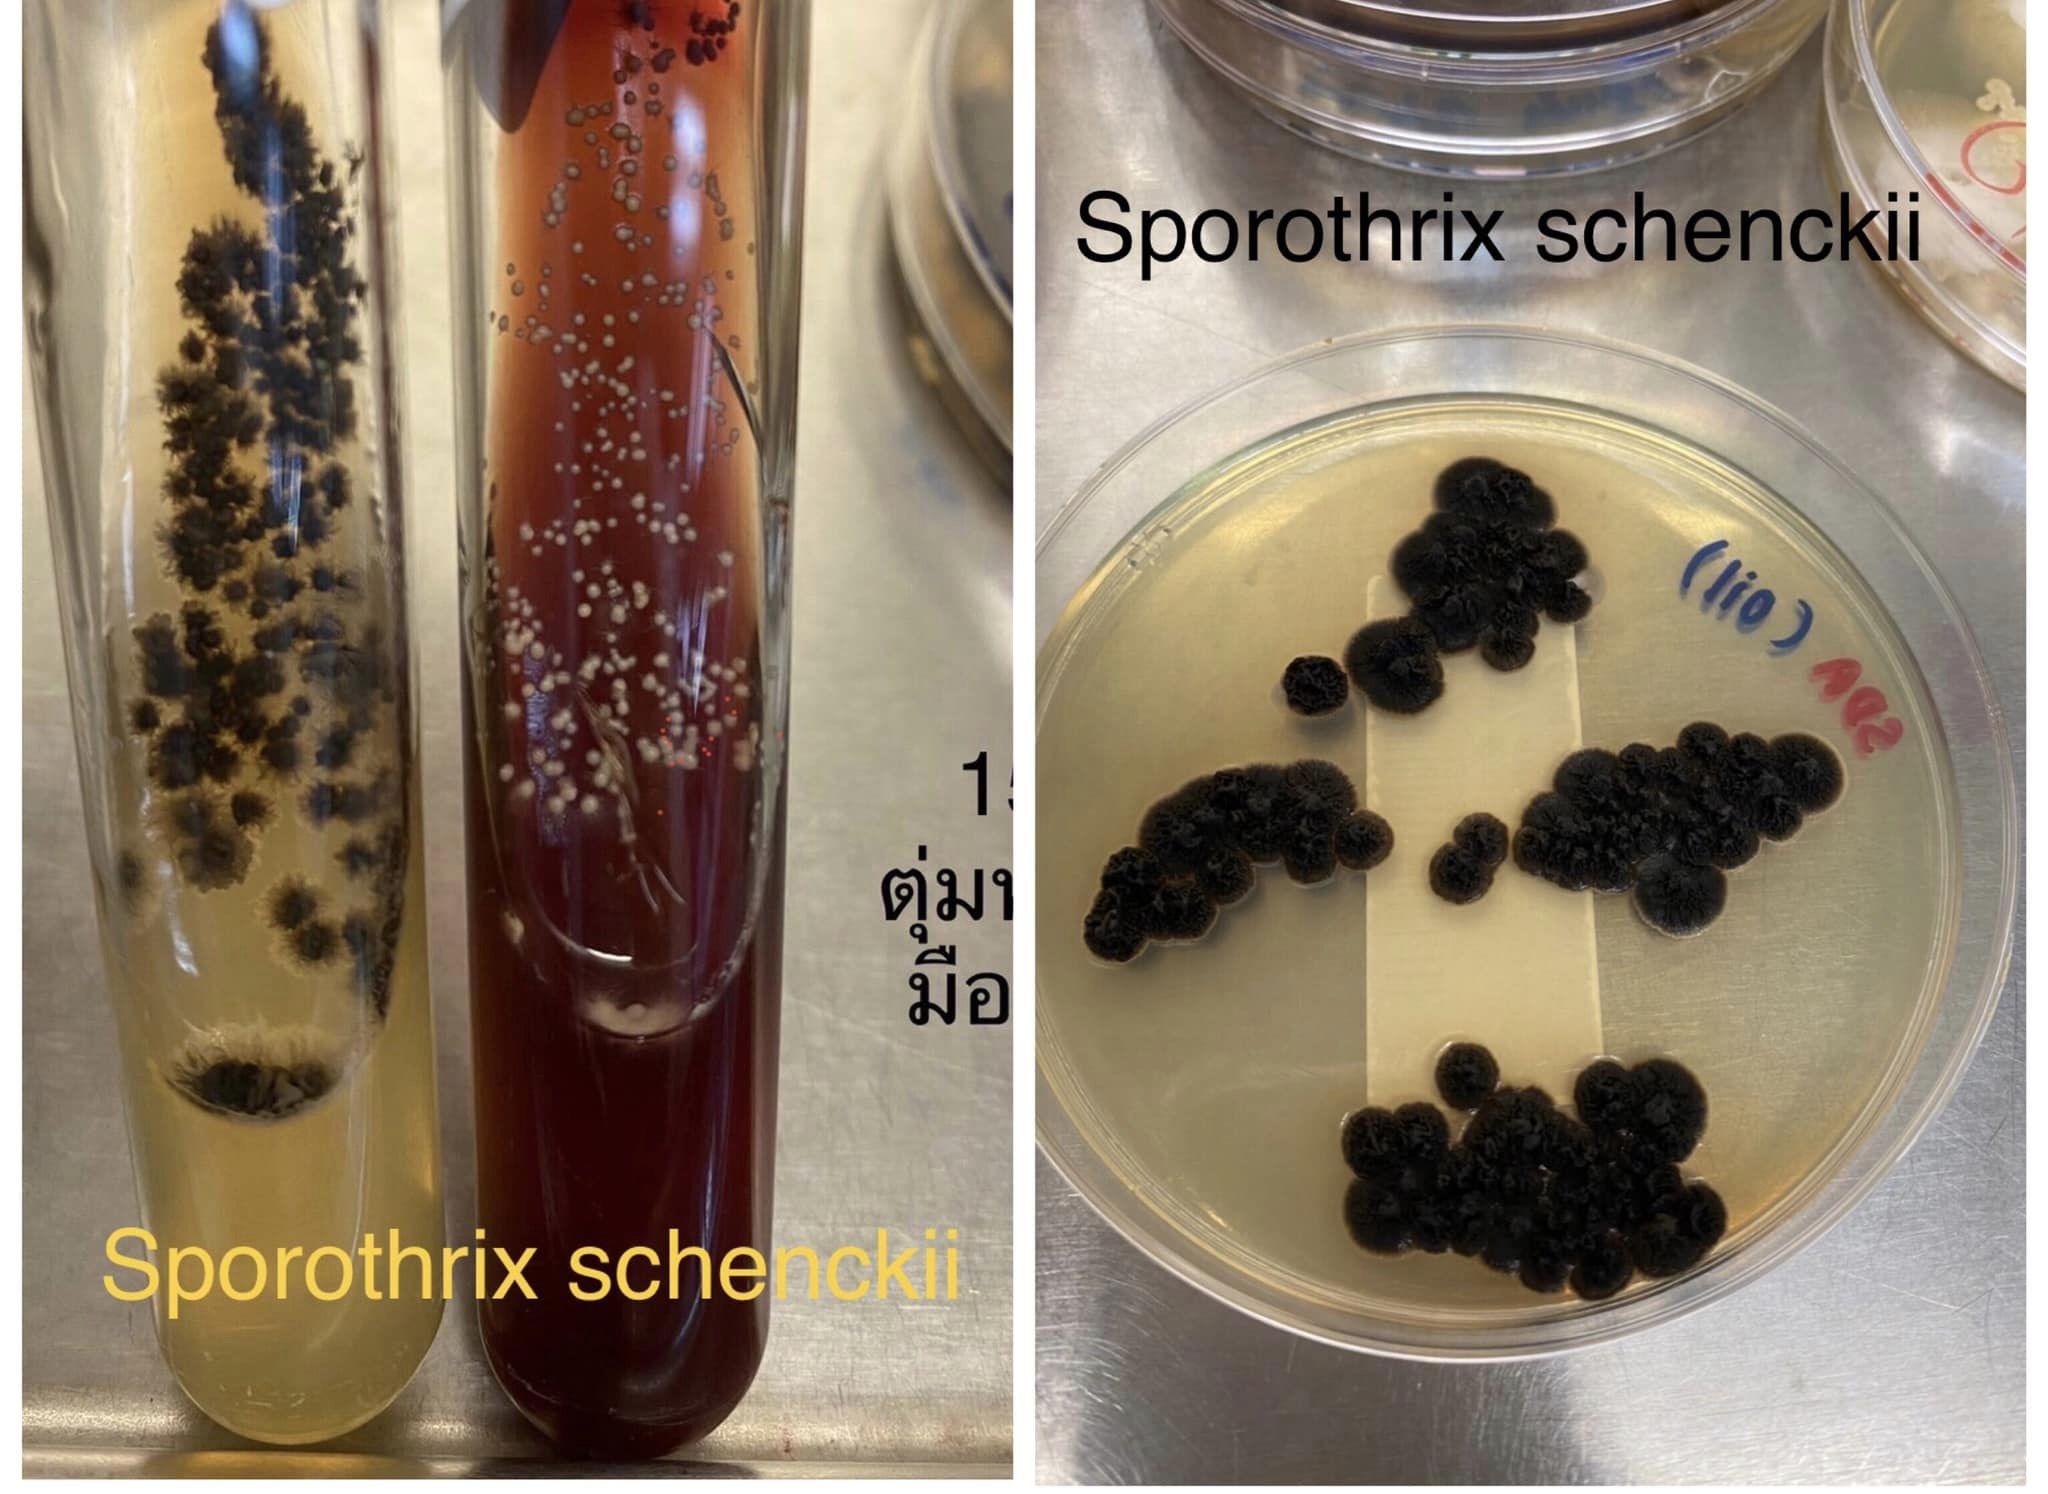

19 ก.ย. 65 นพ.มนูญ ลีเชวงวงศ์ แพทย์เฉพาะทางด้านโรคระบบการหายใจ โพสต์ผ่านเฟซบุ๊ก เผยถึง โรคสปอโรทริโคซิส (Sporotrichosis) เกิดจากเชื้อราซึ่งพบในธรรมชาติ เข้าร่างกายทางบาดแผลจากการถูกแมวกัดหรือข่วน หรือถูกหนามกุหลาบตำ พบไม่บ่อย โรงพยาบาลวิชัยยุทธพบผู้ป่วยโรคนี้ 3 รายใน 1 ปี
ผู้ป่วยหญิงอายุ 51 ปี ใส่ถุงมือให้อาหาร และทำความสะอาดแมวจรจัดที่ป่วยมีแผลตามตัว ถูกเล็บแมวจิกที่หลังมือข้างซ้ายทะลุถุงมือ ทำให้เกิดแผล แมวตัวนี้อยู่ในเขตเมืองของกทม.เสียชีวิตหลังจากนั้น 1 สัปดาห์ หลังทายาปฏิชีวนะแผลที่มือหาย แต่ 2 สัปดาห์ต่อมาวันที่ 13 พ.ค. 2565 เริ่มสังเกตมีตุ่มแดงที่หลังมือซ้ายไม่เจ็บ (ดูรูป) มาพบแพทย์ ตรวจร่างกายพบตุ่มแดงขนาด 0.5 ซม.ที่หลังมือข้างซ้าย ตรงกลางมีหนองเล็กๆ ต่อมน้ำเหลืองไม่โต
แพทย์ใช้เข็มเจาะดูดหนองได้เล็กน้อย ส่งย้อมแบคทีเรีย เชื้อรา พบยีสต์จำนวนมาก (yeast cells) ได้เริ่มยาฆ่าเชื้อรา Itraconazole 100 มก.วันละ 2 ครั้ง วันที่ 23 ก.ค. 65 ผลเพาะเชื้อรา ขึ้นเชื้อรา Sporothrix schenckii กินยา Itraconazole ตั้งแต่ 13 พ.ค.- 16 ก.ย. 65 ในที่สุดแผลแห้งดี (ดูรูป)
ผู้ป่วยรายที่ 2 เกิดจากหนามกุหลาบเกี่ยวผิวหนังที่แขนด้านขวาบน
ผู้ป่วยรายที่ 3 เลี้ยงแมว แต่ปฏิเสธถูกแมวข่วนหรือกัด เป็นที่ผิวหนังแขนข้างซ้าย

เชื้อรา Sporothrix schenckii อยู่ในธรรมชาติ มีแหล่งอาศัยอยู่ตามดิน ตามพืช และเปลือกต้นไม้ เข้าร่างกายทางบาดแผลที่ถูกหนามตำหรือใบไม้บาด หรือจากการถูกแมวที่ป่วยด้วยโรคนี้กัดหรือข่วน
เชื้อรานี้เมื่ออยู่ในร่างกายอุณหภูมิ 37 องศาเซลเซียส ดูด้วยกล้องจุลทรรศน์ มีลักษณะเป็นยีสต์ ถ้าอยู่ตามธรรมชาตินอกร่างกายอุณหภูมิต่ำกว่า จะมีลักษณะเป็นราสาย (ดูรูป)
การรักษาโดยทั่วไปใช้ยาฆ่าเชื้อราชนิดกิน Itraconazole นาน 3-6 เดือนจนกว่าแผลจะหาย
(ขอบคุณอาจารย์ ดร.พิริยาภรณ์ จงตระกูล ที่ปรึกษาแผนกจุลชีววิทยาโรงพยาบาลวิชัยยุทธ)

ร่วมแสดงความคิดเห็น